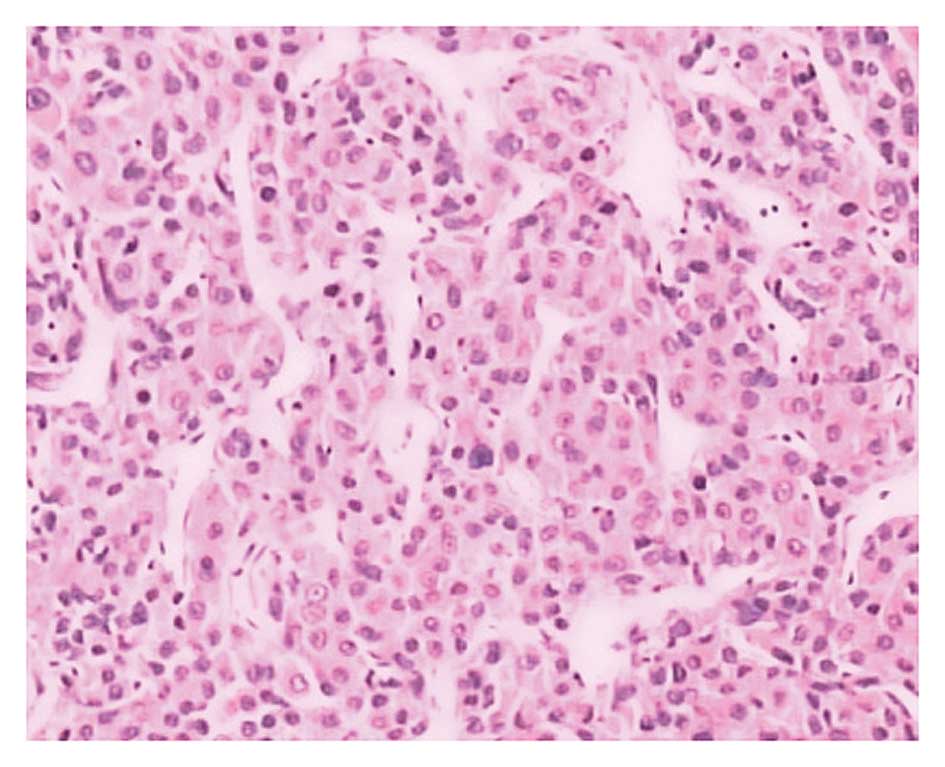

Introduction
Hepatocellular carcinoma (HCC) is the third most
common malignant tumor worldwide, accounting for 6% of all tumors,
with a five-year survival rate of ~10% (1,2). HCC has a
number of characteristics that this poor survival rate may be
attributed to, including fast infiltrating growth, high-grade
malignancy, early-stage metastasis and a poor therapeutic efficacy.
At present, no optimal screening modalities have been established
and HCC is monitored by abdominal ultrasound examinations every 6
months, despite this technique exhibiting inadequate sensitivity.
The optimum treatment for HCC is orthotopic liver transplantation
(OLT), however, other treatment modalities are also available,
which include surgery (resection and liver transplantation),
radiological techniques, systemic chemotherapy and molecularly
targeted therapies (3). Numerous HCC
patients succumb to their condition quickly due to the rapid tumor
progression and metastasis (4). HCC
can metastasize to the lungs, bones, adrenal glands, brain and
other organs and tissues. However, even in patients with advanced
unresectable HCC, the rate of extrahepatic metastasis is limited
(5). According to previous studies, a
primary site is not established in 2–5% of all newly diagnosed
cancer patients with metastases, even following a complete
diagnostic work-up (6). To date,
there have been no studies on HCC metastases in which no primary
foci can be found. Therefore, the current study presents a case of
liver carcinoma metastatic to the thoracic duct with an unknown
primary site and discusses the relevant diagnostic
probabilities.
Case report
A 48-year-old female was admitted to the Department
of Spine Surgery (Zhongda Hospital, Southeast University, Nanjing,
Jiangsu, China) in December 2011, presenting with chest
paraesthesis of the back and numbness of the right lower limb.
Walking distance was also shortened significantly compared with
that of the previous 6 months. A physical examination showed
nothing wrong, with the exception that the bilateral knee jerk and
Achilles tendon reflex were active. Upon admission, magnetic
resonance imaging (MRI) of the thoracic spine and cervical spine
indicated the degeneration of the cervical vertebrae, mild
protrusion of intervertebral discs at C3/4, 5/6 and 6/7, and a
subdural extramedullary high-intensity signal at the T3 level that
was highly suspected to be a lipoma (Fig.
1). Computed tomography (CT) scans and two-dimensional
reconstruction also indicated a low intensity signal in the spinal
canal at the T3 level and strengthened the probability of a lipoma
diagnosis.
The patient received posterior surgery via a
intramedullary tumor resection at the T3 vertebra, internal
fixation of screws at the T2-4 pedicle, bone graft fusion between
the transverse processes and intradural exploration. The spinal
cord was expanded and during the exploration, a yellowish soft mass
was found in the T3 spinal canal. The mass was ~4×4×20 mm and was
well defined. The mass was isolated from the spine gradually until
no tissue residue remained and no clear hemorrhage from the wound
surface was left. Unexpectedly, the post-operative
histopathological examination revealed a moderately-differentiated
HCC (Fig. 2). Immunohistological
examination results were as follows: Cytokeratin (CK)19(−),
Hep1(+), glypican-3(+), cluster of differentiation (CD)10(+),
CK7(−), synaptophysin(−), chromogranin A(−), IMP-3(−) and CD56(−),
with a Ki-67 of ~6%, which was in accordance with the diagnosis of
HCC. As the pathological diagnosis was not in agreement with the
imaging diagnosis and intraoperative exploration, the pathologist
suggested further examinations of the liver.
Subsequent examinations were performed to yield
further information to base the developing diagnosis on. Several
tumor markers were negative, including α-fetoprotein (AFP),
carcinoembryonic antigen, cancer antigen (CA)19-9, CA12-5 and
CA15–3. These tumor markers were measured again 1 month later and
were again found to be negative. Tests for the antigens and
antibodies of hepatitis B and C were all negative. Abdominal B-mode
ultrasound indicated that the liver was normal and no abnormal
signals were observed. Examinations after 3 months and again after
12 months by abdominal B-mode ultrasound showed no subsequent
anomalies. Upper abdominal plain and enhanced CT scans revealed a
slightly lower density mass in the right hepatic lobe that was not
well defined. The mass was ~9×7 mm, and as the only anomaly within
the liver, this site was suspected as the primary liver hemangioma
(Fig. 3), however, no positive
diagnosis could be made. The patient had no history of chronic
liver disease in the past.
The post-operative neurological symptoms improved
greatly and the chest pain was relieved significantly. The patient
refused any further examinations regarding the disease and was
discharged from the hospital. A post-operative follow-up
examination was performed at 3 months, 6 months, 1 year and 1.5
years. The chest paraesthesis and numbness of the right lower limb
were greatly relieved and there were no persistent physiological
symptoms. Written informed consent was obtained from the patient
prior to the publication of the data.
Discussion
HCC presenting as thoracic duct metastasis with an
unknown primary site is extremely rare. In the present study, the
patient exhibited no typical clinical presenting symptoms
associated with HCC, such as liver pain, fatigue, jaundice, palmar
erythema or gynecomastia. Early-stage HCC can be asymptomatic or
patients can only have mild cancer-related symptoms (7). Once a patient presents with liver
carcinoma-related symptoms, it is almost certain that the
individual is in the intermediate or advanced stages of the
disease. A number of techniques are available for the treatment of
intermediate-stage disease, including surgery, transarterial
chemoembolization, radioembolization and radiofrequency ablation
(8).
Given the clinical presentation and imaging results
of the patient in the present study, lipomyoma was the most likely
diagnosis. During surgery, a yellowish soft mass was found and
removed from the spinal canal. This was believed to be the mass
indicated by the MRI in Fig. 1,
unfortunately no sample was preserved after removal. Unexpectedly,
the immediate histopathological examination revealed a
moderately-differentiated HCC. Pathological diagnosis is considered
as the gold standard diagnostic technique, however, the results
were not in accordance with the previous imaging diagnosis and
intraoperative exploration findings. The pathology results were
rechecked three times, yet each time the results pointed to an HCC.
The immunohistochemical markers indicated that it was
moderately-differentiated, yet subsequent laboratory examinations
indicated almost nothing abnormal in the patient's liver. CT was
the only modality that indicated a small area of slightly lower
density in the right hepatic lobe, measuring ~9×7 mm. This region
was highly suspicious, however, tumor markers were negative and
abdominal ultrasound suggested normal tissue. The patient continued
to undergo abdominal ultrasound scans every 6 months without any
indication of anomalies. Given that ultrasound is an extremely
sensitive indicator for liver carcinoma, this led us to conclude
that no primary site within the liver could be located that agreed
with the pathology results. According to the CT results and the
pathological examination, we have several hypotheses about the
primary site. Firstly, in the embryonic period of the patient, the
gene-mutated liver cancer cells may have metastasized or been
implanted in the spinal canal, and over time the tumor mass would
have compressed the spinal canal and the patient would begin to
express symptoms. Secondly, the low-density mass in the liver found
by CT could have been the primary foci, but due to the small size,
examinations may have failed to recognize that it was a tumor mass.
It is also possible that the size of the primary tumor affected the
tumor marker test, as the AFP sensitivity decreases from 52 to 25%
as the tumor diameter decreases below 3 cm (9).
According to previous studies, metastatic disease
occurs in approximately one-third of all advanced cancers and the
primary site of origin is initially uncertain in a number of these
patients. Cancer registries around the world report the incidence
of cancer of unknown primary (CUP) in the range of 2–10% of all
cancer diagnoses (10,11). Furthermore, CUP is among the top 10
most common malignancies (11).
According to large postmortem cohort studies, the most common
primary sites of CUP include the lungs (27%), pancreas (24%), liver
or bile ducts (8%) (12). The
majority of studies on tumors of unknown primary site are of
malignant melanoma, yet reports of liver carcinoma with no primary
foci are seldom mentioned. Recently, Boussios et al
(13) reported a similar case of
neuroendocrine carcinoma of unknown primary site, however, in
contrast to the current study, the patient received palliative
radiation to relieve local symptoms and achieved a partial
response. The follow-up examinations in the present study indicated
that the patient lived healthily and exhibited no liver
carcinoma-associated symptoms post-surgery.
To the best of our knowledge, this is the first
study to report a liver carcinoma patient who had thoracic duct
metastasis with an unknown liver primary site and no associated
clinical symptoms. All the examinations performed suggested that
there was almost nothing abnormal with the patient's liver. Yet the
pathology strongly suggested the presence of liver carcinoma, while
ultrasound and tumor markers were negative. CT suggested an
extremely small area of decreased signal in the right hepatic lobe,
but the diagnosis may have been hampered by the small size of the
possible primary foci. Extensive post-surgery examinations over 1.5
years showed no change in the liver and no presentation of
associated symptoms. Due to its rarity, this case has been
documented to the best of our abilities.
Acknowledgements
The authors would like to thank the reviewers and
editors for their contributions to improving the quality of the
manuscript. The study was supported by the National Natural Science
Foundation of China (grant nos. 81170492 and 81370673), the Key
Medical Projects of Jiangsu Province (grant no. BL2014078) Key
Discipline of Jiangsu Medicine (2011–2015) and, in part, by the
Victorian Government of Australia in the form of a Victorian
Postdoctoral Research Fellowship.
References
|
1
|
Yang JD and Roberts LR: Hepatocellular
carcinoma: A global view. Nat Rev Gastroenterol Hepatol. 7:449–458.
2010. View Article : Google Scholar
|
|
2
|
El-Serag HB: Epidemiology of viral
hepatitis and hepatocellular carcinoma. Gastroenterology.
142:1264–1273. 2012. View Article : Google Scholar : PubMed/NCBI
|
|
3
|
Attwa MH and El-Etreby SA: Guide for
diagnosis and treatment of hepatocellular carcinoma. World J
Hepatol. 7:1632–1651. 2015. View Article : Google Scholar : PubMed/NCBI
|
|
4
|
Jain S, Singhal S, Lee P and Xu R:
Molecular genetics of hepatocellular neoplasia. Am J Transl Res.
2:105–118. 2010.PubMed/NCBI
|
|
5
|
Jarnagin WR: Management of small
hepatocellular carcinoma: A review of transplantation, resection
and ablation. Ann Surg Oncol. 17:1226–1233. 2010. View Article : Google Scholar : PubMed/NCBI
|
|
6
|
Petrakis D, Pentheroudakis G, Voulgaris E
and Pavlidis N: Prognostication in cancer of unknown primary (CUP):
Development of a prognostic algorithm in 311 cases and review of
the literature. Cancer Treat Rev. 39:701–708. 2013. View Article : Google Scholar : PubMed/NCBI
|
|
7
|
Raza A and Sood GK: Hapatocellular
carcinoma review: Current treatment, and evidence-based medicine.
World J Gastroenterol. 20:4115–4127. 2014. View Article : Google Scholar : PubMed/NCBI
|
|
8
|
Bruix J, Gores GJ and Mazzaferro V:
Hepatocellular carcinoma: Clinical frontiers and perspectives. Gut.
63:844–855. 2014. View Article : Google Scholar : PubMed/NCBI
|
|
9
|
Saffroy R, Pham P, Reffas M, Takka M,
Lemoine A and Debuire B: New perspectives and strategy research
biomarkers for hepatocellular carcinoma. Clin Chem Lab Med.
45:1169–1179. 2007. View Article : Google Scholar : PubMed/NCBI
|
|
10
|
Greco FA and Hainsworth JD: Cancer of
unknown primary siteCancer: Principles and Practice of Oncology.
DeVita VT Jr, Hellman S and Rosenberg S: 8th. Lippincott, Williams
& Wilkins; Philadelphia, PA: pp. 2363–2387. 2008
|
|
11
|
Greco FA, Oien K, Erlander M, Osborne R,
Varadhachary G, Bridgewater J, Cohen D and Wasan H: Cancer of
unknown primary: Progress in the search for improved and rapid
diagnosis leading toward superior patient outcomes. Ann Oncol.
23:298–304. 2012. View Article : Google Scholar : PubMed/NCBI
|
|
12
|
Pentheroudakis G, Golfinopoulos V and
Pavlidis N: Switching benchmarks in cancer of unknown primary: From
autopsy to microarray. Eur J Cancer. 43:2026–2036. 2007. View Article : Google Scholar : PubMed/NCBI
|
|
13
|
Boussios S, Kostadima V, Batistatou A, et
al: Neuroendocrine cell carcinoma of unknown primary arising in
long standing history of multiple sclerosis. Case Rep Oncol Med.
2015:1359762015.PubMed/NCBI
|